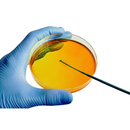
Alça Calibrada 1UL Estéril 100un - Laborcare

- À vista Total:
- 2x Total:
- 3x Total:
- 4x Total:
- 5x Total:
- 6x Total:
- 7x Total:
- 8x Total:
- 9x Total:
- 10x Total:
- 11x Total:
- 12x Total:





Parcele suas compras
Nas melhores bandeiras





Descrição
SOBRE NÓS
- Já vendemos há 15 anos na internet.
- Somos distribuidores autorizados de todas as marcas no nosso estoque.
- Emitimos nota fiscal para todas as nossas vendas.
- Compre de quem é confiável como nós e desconfie de ofertas fora da realidade.
SOBRE SEU PEDIDO
- Envio em até 12 horas.
- Embalagens super reforçadas para o seu pedido não chegar amassado.
- Grande estoque disponível para envio imediato e direto da fábrica.
DÚVIDAS?
- Fale conosco e nossos consultores especializados irão te atender imediatamente.
- Veja as imagens do produto, lá tem muitas informações importantes.
- Leia toda a descrição antes de efetuar a sua compra.
DETALHES
- Produto: Alça Calibrada.
- Marca: Labor Import.
- Material: Polipropileno.
- Linha: Premium.
- Tamanho: 1 UL.
- É estéril: Sim.
- Contém: 100 unidades.
- Registro Anvisa: Sim.
- Fácil manipulação.
- Mais praticidade de uso.
- Descartável.
- Higiênico.
- Alta durabilidade.
- Ideal para ambiente hospitalar.
- Alta qualidade.
SKU 3347